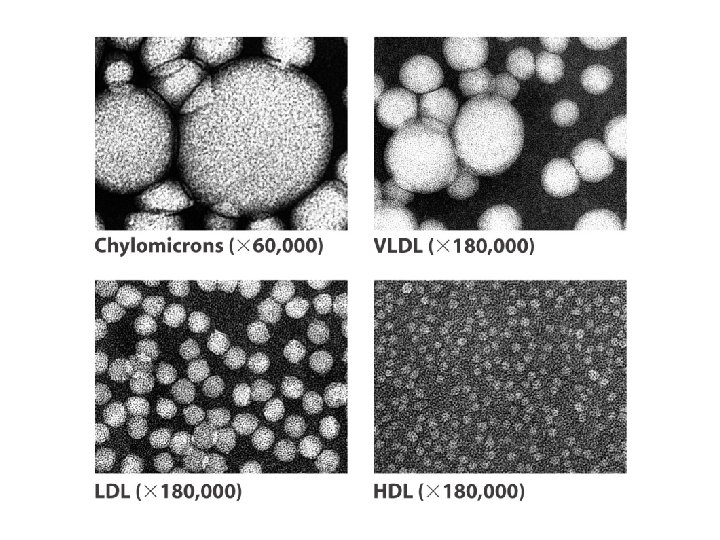

Lipogenesis Glycerol 3 phosphatedihydroxy acetone phosphateacylCo A Phospholipase

- Slides: 124
• 脂合作用(Lipogenesis) : Glycerol 3 phosphate或dihydroxy acetone phosphate與三個分子的acyl-Co. A反應 形成三酸甘油酯。
磷脂的分解 • Phospholipase可以催化水解 Phosphoglyceride分子,依據水解位置的 不同,可區分為phospholipase A 1、A 2、C 與D。 • Sphingolipid 的代謝 • Sphigosine是由Palmitoyl-Co. A與Serine開 始合成,加入acyl基後再氧化成ceramide, 再與phosphatidylcholine作用形成 sphingomyelin。
Lipid biosynthesis • Biosynthesis of fatty acids and eicosanoids • Biosynthesis of triacylglycerol • Biosynthesis of membrane phospholipids • Biosynthesis of cholesterol, steroids, and isoprenoids
The acetyl-Co. A carboxylase reaction
The mammalian FAS I • Seven active sites for different reactions lie in separate domain. • The mammalian polypeptide functions as a homodimer (Mr. 480, 000). • The subunits appear to function independently. When all the active sites in one subunit are inactivated by mutation, fatty acid synthesis is only modestly reduced.
The structure of fatty acid synthase type I system
Acyl carrier protein (ACP) The 4’-phosphopantetheine prosthetic group of ACP serves as a flexible arm, tethering the growing fatty acyl chain to the surface of the fatty acid synthase complex while carrying the reaction intermediates from one enzyme active site to the next.
Sequence of events during synthesis of a fatty acid • The acetyl group of acetyl -Co. A is transferred to ACP in a reaction catalyzed by MAT. The acetyl group is then transferred to the Cys-SH group of the b-ketoacyl. ACP synthase (KS). • MAT: Malonyl/acetyl-Co. A -ACP transferase
• The enzyme shown in color is the one that will act in the next step.
Beginning of the second round of the fatty acid synthesis cycle
The overall reaction for synthesis of palmitate from acetyl-Co. A 1. 7 Acetyl-Co. A + 7 CO 2 + 7 ATP → 7 malonyl-Co. A + 7 ADP + 7 Pi 2. Acetyl-Co. A + 7 malonyl-Co. A + 14 NADPH + 14 H+ →palmitate + 7 CO 2 + 8 Co. A + 14 + NADP+ + 6 H 2 O 8 Acetyl-Co. A + 7 ATP + 14 NADPH + 14 H+ → palmitate + 8 Co. A + 7 ADP + 7 Pi + 14 NADP+ + 6 H 2 O
Subcellular localization of lipid metabolism
Production of NADPH
• 大量的NADPH是合成脂肪酸必需的,胞 質中NADPH的來源: • 1 pentose phosphate pathway (佔大 部分) • 2 malic enzyme
Shuttle for transfer of acetyl groups from mitochondria to the cytosol
• Acetyl-Co. A carboxylase的調控 • Acetyl-Co. A carboxylase包含兩條 subunit(dimer),每一條sunbit上皆有 biotin。當dimer聚合成polymer後(如檸檬 酸增加),催化反應進行。當malonyl-Co. A 成Palmitoyl-Co. A增加時聚合作用被抑制。
• 昇糖素與腎上腺素的作用會磷酸化 Acetyl-Co. A carboxylase導 depolymeration。
脂肪酸的分解(β-oxidation)與合 成的差異 • 1 Location(位置): 脂肪酸合成位置在細胞質,β -oxidation則在粒線體與peroxisome。 • 2 Enzyme: 催化合成與β-oxidation的酵素是不同 的 • 3 Thioester linkage不同: 脂肪酸合成acylcarrier是ACP蛋白,而β-oxidation則是Co. A-SH。 • 4 Electron carriers: β-oxidation可以產生 NADH與FADH 2,脂肪酸合成則消耗NADPH。
The triacylglycerol cycle
Glucocorticoid hormones regulate the levels of PEP carboxykinase reciprocally in the liver and adipose tissue (a biological steroid) (a synthetic glucocorticoid)
Glucocorticoid • Acting through the glucocorticoid receptor, tissue steroid hormones increase the expression of the gene encoding PEP carboxykinase in liver, increasing gluconeogenesis and glyceroneogenesis. • Stimulation of glyceroneogenesis leads to an increase in the synthesis of triacylglycerol molecules in the liver and their release into the blood. • Suppress the expression of gene encoding PEP carboxykinase in adipose tissue; recycling of fatty acids declines as a result, and more free fatty acids are released into the blood. • Affecting lipid metabolism in opposite ways: a lower rate of glyceroneogenesis in adipose tissue leads to more fatty acid release, whereas a higher rate in the liver leads to more synthesis and export of triacylglycerols. • The net result is an increase in flux through the triacylglycerol cycle.
Regulation of glyceroneogenesis PEPCK: PEP carboxykinase
Connection between glyceroneogenesis and diabetes • High levels of free acids in the blood interfere with glucose utilization in muscle and promote the insulin resistance that leads to type 2 diabetes. • A new class of drugs called thiazolidinediones have been shown to reduce the levels of fatty acids circulating in the blood and increase sensitivity to insulin
Thiazolidinediones • Bind to and activate a nuclear hormone receptor called peroxisome proliferator-activated receptor g (PPARg), leading to the induction in adipose tissue of PEP carboxykinase. • A higher activity of PEP carboxykinase then leads to increased synthesis of the precursors of glyceroneogenesis, which in turn increases the resynthesis of triacylglycerol in adipose tissue and reduces the release of free fatty acid from adipose tissue into blood.
Thiazolidinediones used to treat type 2 diabetes
動物中的脂肪酸代謝的調控 • 脂肪酸的代謝受到嚴密的控制 • 1 Allosteric effect • (一)Citrate 促進Acetyl-Co. A → Malonyl-Co. A的 酵素,能促進acetyl-Co. A carboxlase活性,脂肪 酸的合成 • (二)Malonyl-Co. A 抑制Acyl-Co. A進入粒線體(因為 Malonyl-Co. A能抑制carnitine acyltransferase I的活性。 • (三)Palmitoyl-Co. A : 1抑制pentose phosphate pathway。2抑制脂肪酸合成,抑制acetyl-Co. A carboxlase。
Long-Chain saturated fatty acids are synthesized from palmitate • Palmitate, the principal product of the fatty acid synthase system in animal cells, is the precursor of other longchain fatty acids. • It may be lengthened to form stearate or even longer saturated fatty acids by further additions of acetyl groups, through the action of fatty acid elongation systems present in the smooth endoplasmic reticulum and in mitochondria. • Although different enzyme systems are involved, and coenzyme A rather than ACP is the acyl carrier in the reaction, the mechanism of elongation in the ER is otherwise identical to that in palmitate synthesis: donation of two carbons by malonyl-Co. A, followed by reduction, dehydration, and reduction to saturated 18 carbon product, stearoyl-Co. A.
Routs of synthesis of other fatty acids • Mammals cannot convert oleate to linoleate or alinolenate (shaded pink). • Linoleate and alinolenate are essential fatty acids for mammals; they must be obtained from dietary plant material.
Electron transfer in the desaturation of fatty acids in vertebrates • Occurred on the lumenal face of the smooth ER • Catalyzed by fatty acid-Co. A desaturase, a mixed -function oxidase.
Routs of synthesis of other fatty acids • Mammals cannot convert oleate to linoleate or alinolenate (shaded pink). • Linoleate and alinolenate are essential fatty acids for mammals; they must be obtained from dietary plant material.
Action of plant desaturases
The “ cyclic” pathway from arachidonate to prostaglandins and thromboxanes • Cyclooxygenase (COX), also called prostaglandin H 2 synthase, is the enzyme of the smooth ER. • Aspirin (acetylsalicylate) irreversibly inactivates the cyclooxygenase activity of COX by acetylating a Ser residue and blocking the enzyme’s active site, thus inhibiting the synthesis of prostaglandins and thromboxanes. • Ibuprofen, a widely used nonsteroidal antiflammatory drug (NSAID), inhibits the same enzyme.
• PLA 2(phospholipase A 2)催化 phosphoglyceride釋出arachidonic acid。 一些類固醇的藥物可以抑制PLA 2的活性, 具有抑制發炎的特性。
磷脂質的合成 細胞膜是由雙層脂質構成,其主要組成為 phospholipid與sphingolipid組成, phospholipid的合成主發生於SER與細胞質。 合成Phosphatidylethanolamine開始於細 胞質,ethanolamine被磷酸化,然後形成 CDP-ehtanolamine,再進入SER中與DAG作 用合成磷脂質。合成 Phosphatidylethanolamine與 Phosphatidylcholine的過程相似。
Biosynthesis of phosphatidic acid The vast major way In liver and kidney
• 神經鞘脂類新陳代謝 – 3'-磷酸腺-5'-磷酸硫酸(3'-phosphoadenosine-5' -phosulfate; PAPS)
Biosynthesis of cholesterol • Cholesterol is doubtless the most publicized lipid, notorious because of the strong correlation between high levels of cholesterol in the blood and incidence of human cardiovascular diseases. • Cholesterol is an essential molecule in many animals, but is not required in the mammalian diet—all cells can synthesize it from simple precursors. • The structure of this 27 -carbon compound suggests a complex biosynthetic pathway, but all of its carbon atoms are provided by a single precursor—acetate. • The isoprene units that are the essential intermediates in the pathway from acetate to cholesterol are also precursors to many other natural lipids.
• 膽固醇是isopentenyl pyrophosphate衍生 物之一,大部分的cholesterol分子在肝中 合成。其合成的步驟: • 1 acetyl-Co. A形成HMG-Co. A • 2轉換HMG-Co. A → Squalene • 3 Squalene → cholesterol
Origin of the carbon atoms of cholesterol
Stage I: Synthesis of mevalonate from acetate
The committed and rate-limiting step HMG-Co. A reductase, an integral membrane protein of the small ER, is the major point of regulation on the pathway to cholesterol.
Overview of isoprenoid biosynthesis
Cholesterol has several fates • Much of the cholesterol synthesis in vertebrates takes place in the liver. A small fraction of the cholesterol made there is incorporated into the membranes of hepatocytes, but most of it is exported in one of three forms: Biliary cholesterol, bile acids, or cholesteryl esters. • Bile acids and their salts are relatively hydrophilic cholesterol derivatives that synthesized in the liver and aid in lipid digestion. • Cholesteryl esters are formed in the liver through ACAT that catalyzes the transfer of a fatty acid from Co. A to the hydroxyl group of cholesterol, converting the cholesterol to a more hydrophobic form. • Cholesteryl esters are transported in secreted lipoprotein particles to other tissues that use cholesterol, or they are stored in the liver.
Synthesis of cholesteryl esters
Structure of a low-density Lipoprotein (LDL)
Lipoproteins and lipid transport
Reaction catalyzed by LCAT
Cholesteryl esters enter cells by receptor-mediated endocytosis • Each LDL particle in the bloodstream contains apo. B-100, which is recognized by specific surface receptorproteins, LDL receptors, on cell that need to take up cholesterol. • The binding of LDL to an LDL receptor initates endocytosis, which conveys the LDL and its receptor into the cell within an endosome. • The endosome eventually fuses with a lysosome, which contains enzymes that hydrolyze the cholesteryl esters, releasing cholesterol and fatty acid into cytosol. • The apo. B-100 of LDL is also degraded to amino acids that are released to the cytosol, but the LDL receptor escapes degradation and is returned to the cell surface, to function again in LDL take. • Apo. B-100 is also present in VLDL, but its receptor-binding domain is not available for binding to the LDL receptor; conversion of VLDL to LDL exposes the receptor-binding domain of apo. B-100. • This pathway for the transport of cholesterol in blood and its receptor -mediated endocytosis by target tissues was elucidated by Michael Brown and Joseph Goldstein.
• The LDL receptor also binds to apo. E and plays a significant role in the hepatic uptake of chylomicrons and VLDL remnants. • If LDL receptors are unavilable, VLDL remnants and chylomicrons are still taken up by the liver even though LDL is not. • This indicates the presence of a back-up system for receptor-mediated endocytosis of VLDL remnants and chylomicrons. • One back-up receptor is lipoprotein receptorrelated protein (LRP), which binds to apo. E as well as to a number of other ligands.
Cholesterol biosynthesis is regulated at several levels • In mammals, cholesterol production is regulated by intracellular cholesterol concentration and by the hormones glucagon and insulin. • The rate-limiting step in the pathway to cholesterol is conversion of HMG-Co. A to mevalonate, the reaction catalyzed by HMG-Co. A redeuctase. • Regulation in response to cholesterol levels is mediated by an elegant system of transcriptional regulation of the gene encoding HMG-Co. A reductase. • This gene, along with more than 20 other genes encoding enzymes that mediate the uptake and synthesis of cholesterol and unsaturated fatty acids, is controlled by a small family of proteins called sterol regulatory element-binding proteins (SREBPs).
Other regulation of cholesterol biosynthesis • Hormonal control is mediated by covalent modification of HMG-Co. A reductase itself. The enzyme exists in phosphorylated (inactive) and dephosphorylated (active) forms. • Glucagon stimulates phosphorylation (inactivation), and insulin promotes dephosphorylation, activating HMGreductase and favoring cholesterol synthesis. • High intracellular concentrations of cholesterol activate ACAT, which increases esterification of cholesterol for storage. • A high cellular cholesterol level diminishes transcription of the gene that encodes the LDL receptor, reducing production of the receptor and thus the uptake of cholesterol from the blood.
• Lovastatin treatment lowers serum cholesterol by as much as 30% in individuals having one defective copy of the gene for LDL receptor. • When combined with an edible resin that binds bile acids and prevents their reabsorption from the intestine, the drug is even more effective.
Inhibitors of HMG-Co. A reductase
• 腦下垂體(pituitary gland)能分泌ATCH能 結合adrenal cell 促進 21 -hydrooxylase、 17 -α-hydroxylase的合成(adrenal cortex)。 • Aldosterone: 與離子平衡有關 • Cortisol: 促進肝中gluconeogenesis、 lipogenesis與amino acid uptake。
圖 12. 28(a)膽酸(cholicacid)的合成